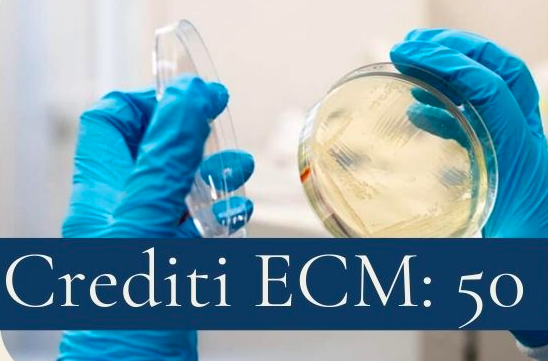

L’ECM rappresenta il percorso obbligatorio di aggiornamento professionale per medici, infermieri e tutti gli operatori sanitari in Italia.
Attraverso corsi, seminari, formazione online e attività sul campo, i professionisti acquisiscono crediti formativi che garantiscono competenza, sicurezza e qualità delle cure offerte.
Obbligo formativo: ogni triennio è necessario conseguire 150 crediti ECM (salvo esoneri o esenzioni).
Scadenze e Recupero Crediti
Il termine per recuperare eventuali debiti del triennio 2020–2022 è prorogato al 31 dicembre 2025.
Chi ha crediti in eccesso nel triennio attuale può spostarli per coprire mancanze pregresse fino al 30 giugno 2026.
Dal 1° gennaio 2026 la regolarità ECM sarà essenziale: molte polizze assicurative richiederanno almeno il 70% dei crediti previsti.
Come Mettersi in Regola
È possibile recuperare i crediti mancanti attraverso diverse modalità:
- Corsi FAD e-learning accreditati.
- Convegni, seminari, workshop e formazione residenziale.
- Formazione sul campo tramite provider accreditati.
- Uso di crediti compensativi o spostamento di crediti in eccesso.
Rischi in caso di mancata Regolarizzazione
Dal 2026, la mancanza del minimo di crediti potrebbe compromettere la validità dell’assicurazione professionale.
Alcuni ordini professionali segnalano possibili ripercussioni su benefici previsti dalla normativa ECM.
Cosa fare subito
- Verificare la propria posizione sul portale Co.Ge.A.P.S. tramite SPID.
- Iscriversi a corsi FAD o eventi formativi per recuperare i crediti mancanti.
- Valutare il riconoscimento di autoformazione, pubblicazioni o eventi passati (se previsti).
Con l’avvicinarsi della scadenza del triennio ECM 2023–2025, è fondamentale che ogni professionista sanitario controlli la propria situazione e, se necessario, agisca tempestivamente. L’ECM non è soltanto un obbligo normativo: è una garanzia di qualità, sicurezza e professionalità per operatori sanitari e pazienti.
I corsi ECM